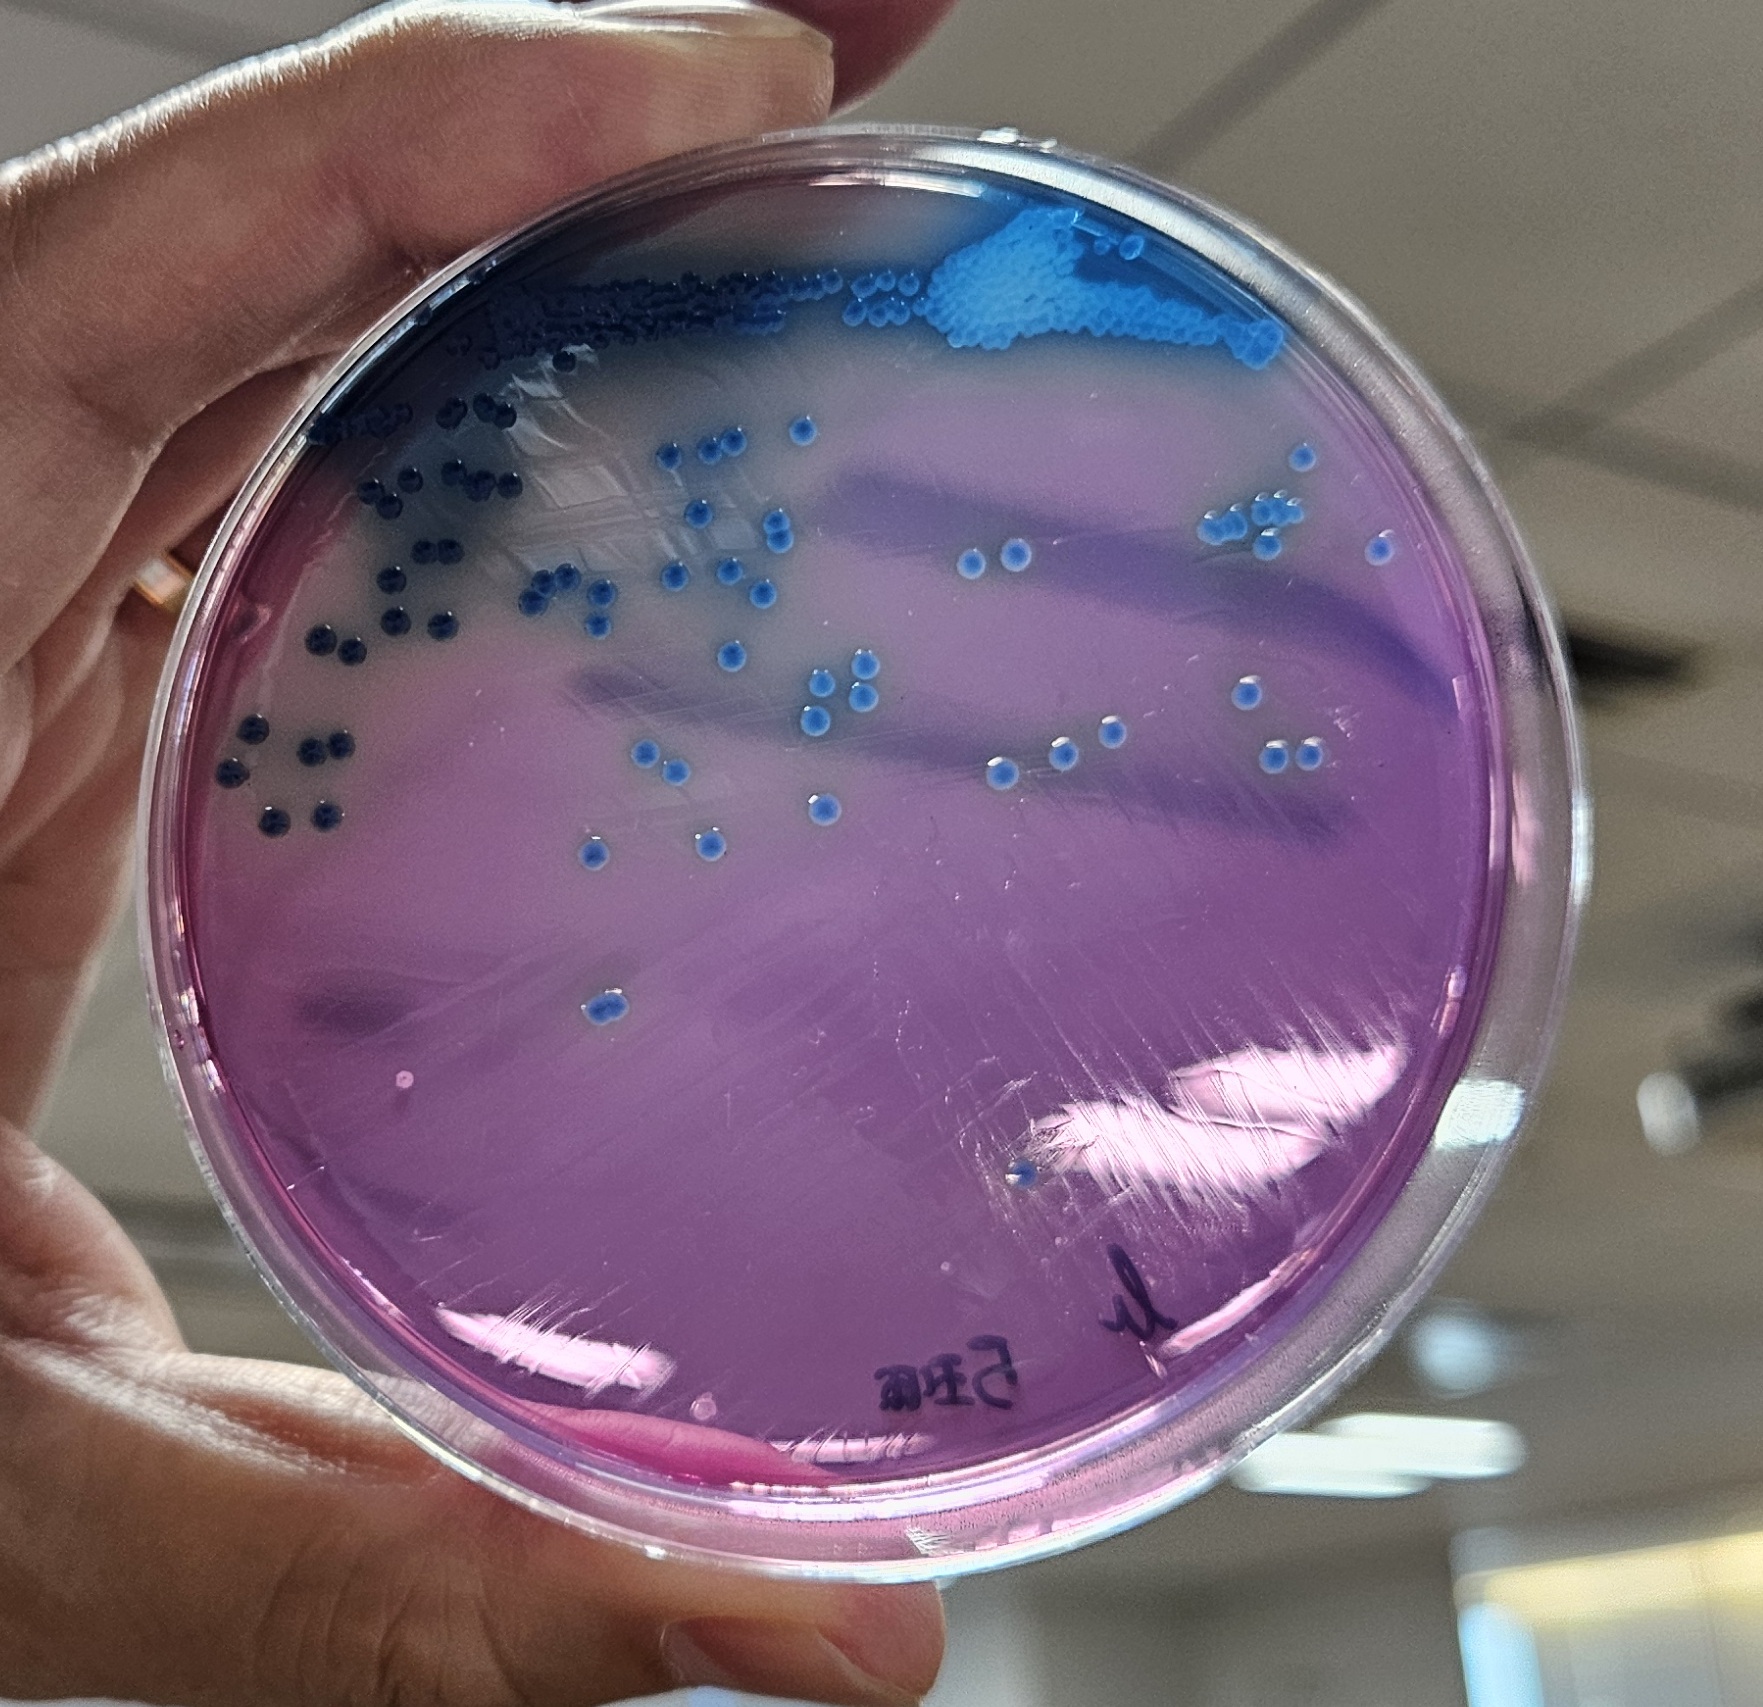
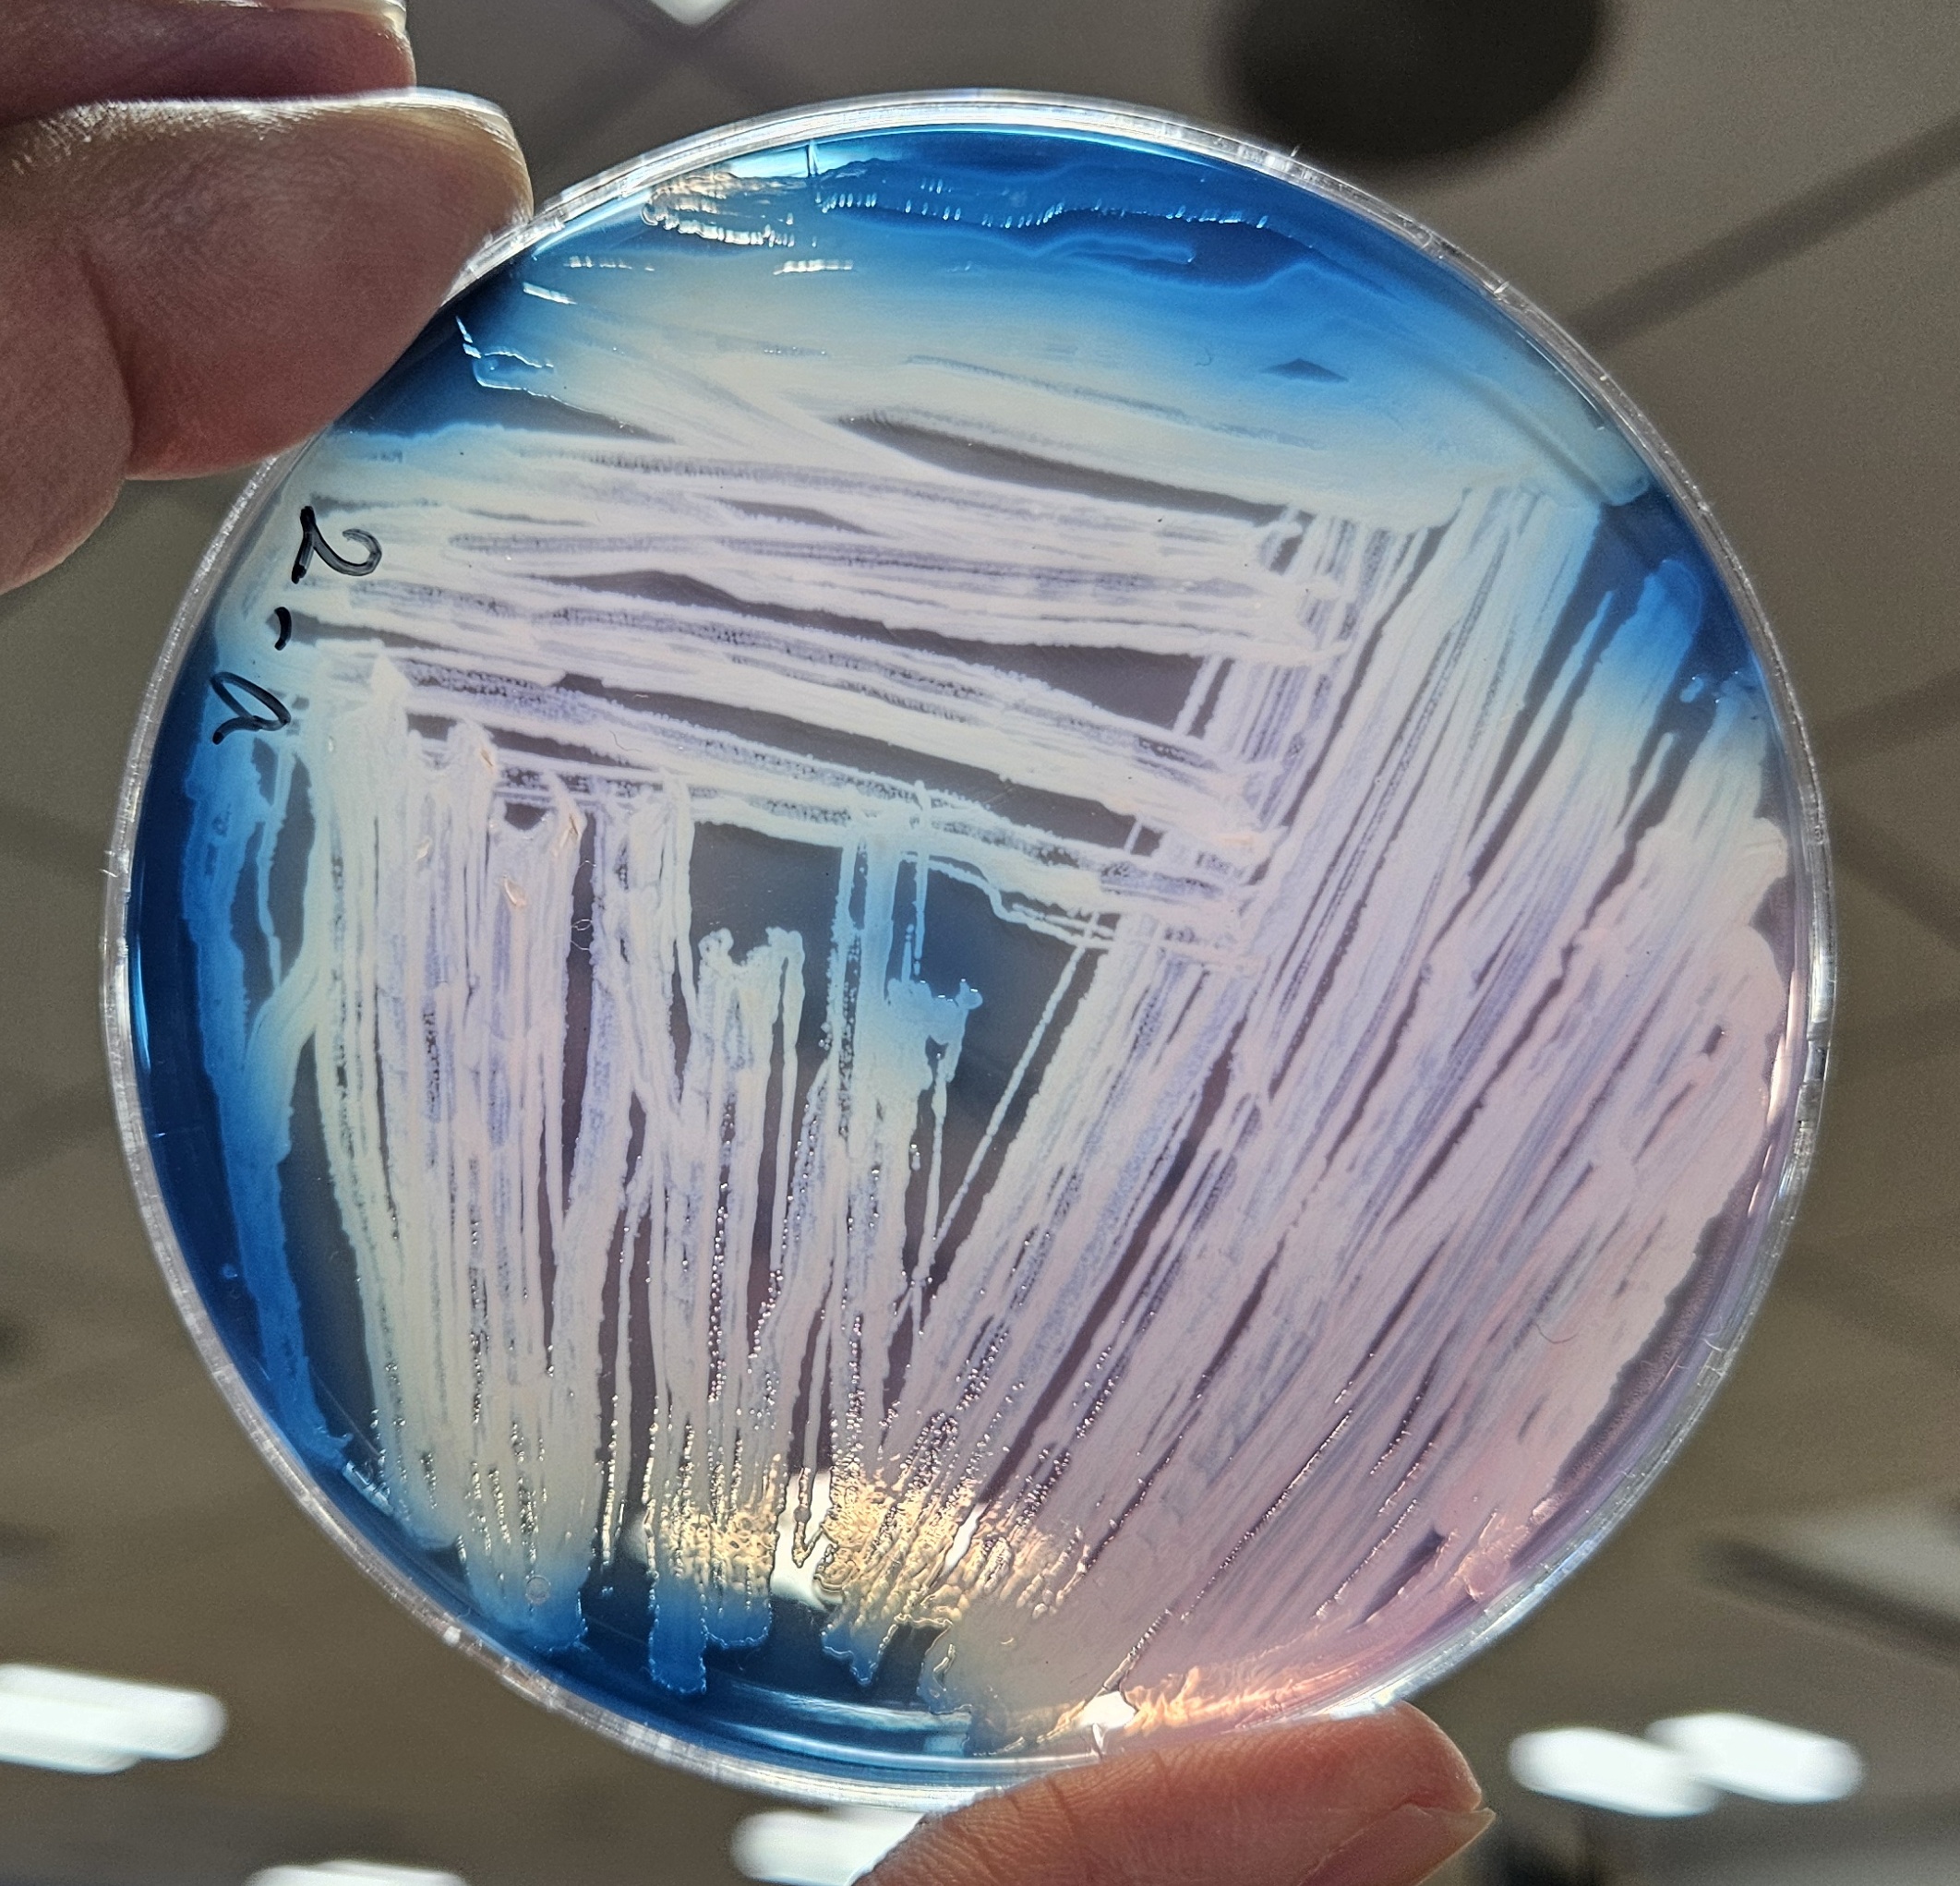
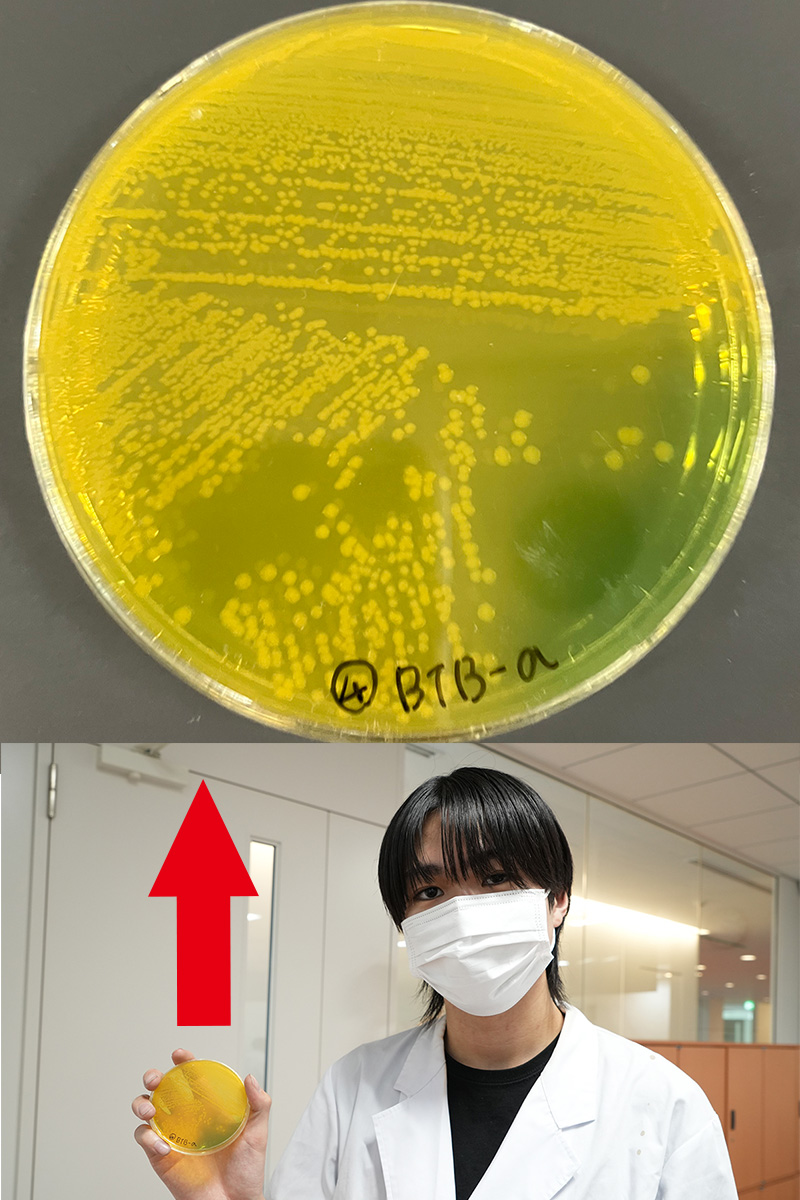

授業風景
2025.10.08
臨床検査学科 臨床微生物検査学実習で細菌の「分離培養」「同定検査」にチャレンジ!
2025.10.08

今回は、2年生の臨床微生物検査学実習の様子をご紹介します!
この授業では、感染症の起因となる微生物の性質を学び、感染症の診断・予防・治療に関する検査法とその技術を身につけます。
*
分離培養とは、様々な微生物の中から、目的に合わせて特定の微生物を取り出し、増殖させる技術のことを言います。
培地(寒天でできています!)に検体を塗抹(塗り広げること)して、同種類の菌の1つの集まりである「単一コロニー」を作ることを目標にします!
そうすることで、検査に必要な微生物を的確に接種、検査、判定することが可能になります。
上手く塗抹するには技術が必要で、最初はなかなか難しいのですが、授業が進むにつれて綺麗に分離ができるようになっていきます。
▼上手にできたケース。丸い点の一つ一つが単一コロニーを形成しています。
▼今後に期待!のケース。全体が繋がって上手く単一コロニーが形成されていません。
*
今回は、免疫力が低下した際に感染症を引き起こす「緑膿菌」の分離培養・同定検査を実施しました!
塗抹の様子です。細かい手作業のため、皆真剣な表情です。

微生物検査では操作(手技)の過程で、環境菌の混入を防ぐ必要があります。このための操作を無菌操作と言い、検査技術の大切な基本となっています。

菌が培養されるのを待ち、翌日に同定検査を行います!
▼上手くできていたので記念撮影!綺麗に単一コロニーができていますね。
▼目的の菌を採取し、顕微鏡を使用してよく観察します!

▼様々な検査を行いました!


理科、化学の実験が好きな方にはとてもワクワクする光景ではないでしょうか?
実習中の学生たちにこの授業のやりがいや楽しいところを尋ねると、「1年次に座学で学んだ微生物の知識が実践に結びついて、同定ができるようになるところ!」とのコメントが返ってきました!
菌によってどのような反応が起きるかという知識は、国家試験に向けても必要になってきます。
国家試験合格に欠かせない微生物検査の知識を、座学だけでなく、目で見て、手を動かし、実体験を通じて身につけていきます!

今回のように、臨床検査学科では、臨床検査技師として必要な知識と技術を楽しみながら身につけられるよう、実践的な授業を積極的に展開しています。
みなさんも東京電子の臨床検査学科の学びの魅力に触れてみませんか?
臨床検査学科の詳細はこちら!
資料請求は画面右下の赤のボタンから!
イベント予約は画面左下の緑のボタンから!
▼東京電子の学びの魅力を体感!イベントの様子▼

※当日の内容はイベントの種類・参加日程により異なる場合があります。
教職員一同、皆さんと一緒に学べる日を楽しみにしています。
新着記事
-


課外活動
臨床工学科 自衛隊で医療現場・設備を見学しました!
今回は臨床工学科1年生が課外活動の一環として、自衛隊中央病院...
2026.05.08
-


資格表彰
臨床工学科 日本臨床工学技士教育施設協議会 代表理事賞を受賞しました!【動画】
臨床工学科の学生が日本臨床工学技士教育施設協議会 代表理事賞...
2026.04.23
-


資格表彰
臨床検査学科 2025年度心電図検定 合格実績!今回も合格者多数!
今回の心電図検定も、たくさんの学生が合格しました! 各級実績...
2026.04.16
-


授業風景
臨床工学科 テルモ株式会社様による腹膜透析の講義・デモンストレーション!
臨床工学科の、医療系メーカー様をお呼びしての特別授業の様子を...
2026.02.12







